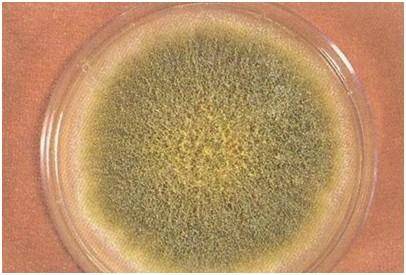

63岁的李先生前段时间早上刷牙时发现牙龈频繁出血。起初,他以为只是上火的缘由,但后来发现即便不刷牙,牙龈依然经常出血。家人认识到状况不对劲,赶忙让他去医院检查。

到了医院,李先生挂了口腔科的号码,医生看了看他的牙齿,却给他开了一系列全身检查。李先生立即表现出不满,以为医生在诈骗他。医生耐烦地解释了一番,直到李先生同意停止检查。
检查结果显现,李先生的白细胞、红细胞和血小板数量都偏低,而且肝脏有一个肿瘤,这招致了李先生牙龈出血的病症。李先生看着厚厚的检查单,感到一片茫然。
一,他关于刷牙出血与肝癌之间的关联感到困惑。
在此提示,不是一切的牙龈出血都与肝癌有关,肝癌只是招致牙龈出血的其中一个缘由。常见惹起牙龈出血的缘由包括:
1、刷牙用力过猛
许多人在刷牙时都会用很大的力气,以为只要这样才干彻底清洁口腔内的残渣和污垢。但是,过度用力的刷牙会形成牙龈损伤,进而招致牙龈出血。特别是那些运用硬毛牙刷的人,更容易呈现出血状况。

2、牙周疾病
一些牙周疾病也会惹起患者呈现异常出血的病症。这些患者在正常进食时,常常会发现咀嚼食物时有血痕呈现。即便悄悄刷牙,也可能呈现出血状况。
3、其他全身性疾病
一些患有严重贫血、白血病和肝癌的患者,也可能呈现牙龈出血的状况。肝癌惹起牙龈出血的缘由是由于患者的肝功用受损,招致体内凝血功用异常。

若日常呈现异常的牙龈出血病症,倡议及时就医停止检查,不要拖延。此外,在肝癌开展时,身体还会发出一系列的“正告”信号,其中一些信号可能会呈现在头部。
二、肝癌降临,头部可能有警示信号
1、鼻子出血
除了提示血液疾病外,鼻腔异常出血也可能是肝癌发出的信号。肝癌会招致肝功用严重受损,进而惹起贫血和出血倾向,诱发鼻出血、黑便和呕血等病症。
2、面色、眼睛发黄
肝癌患者常见的梗阻性黄疸病症表现为皮肤和虹膜异常发黄。肝癌招致肝内胆管局部或完整机械性梗塞,当胆汁无法正常排出时,胆红素会逆流至血液中,并随着血液循环抵达全身,招致皮肤和黏膜呈现异常的黄疸病症。

3、蜘蛛痣
蜘蛛痣因外形相似蜘蛛而得名,在肝功用受损后,代谢才能降落,从而招致蜘蛛痣的呈现。当用手指按压蜘蛛痣的中心时,四周的毛细血管会褪色,松开压力后又会恢恢复样。
除了上述病症外,肝癌还可能惹起腹痛、腹胀、消化不良、恶心呕吐、体重降落和皮肤瘙痒等病症。但是,这些病症并不能确诊为疾病或肝癌,最好的诊断办法依然是依托专业医生和检查。希望大家能对这些病症惹起注重。

中国长期以来不断被称为“肝癌大国”,为什么中国人如此容易患上肝癌?樊嘉院士对此停止理解释。
三、院士忠告:控制4个要素,减少肝癌风险
中国新发肝癌占全球的55%,在全球范围内,肝癌的发病率排名第四,死亡率排名第三,仅有14%的患者可以存活五年。而手术后的转移和复发风险在60%至70%之间。
中国科学院院士樊嘉指出,我国肝癌的高发与四个要素严密相关。
1、乙肝
乙肝、肝硬化和肝癌被称为“乙肝三部曲”,它们之间有着严密的联络。据统计,我国目前有接近1亿的乙肝携带者,这个庞大的人群都面临着患上肝硬化和肝癌的潜在风险。普通状况下,假如不控制病情,局部肝硬化在约15年的时间内可能开展成肝癌。
2、黄曲霉素
在我国,节俭节约的美德不得人心,许多人在发现食物发霉后仍不舍得扔掉,而是选择去除霉变局部后继续食用。但是,他们未认识到霉变食物中可能存在黄曲霉素,而黄曲霉素是一种强致癌物质,长期摄入会增加患肝癌的风险。
3、酒
酒是一种致癌物,过量饮酒会对肝脏形成严重伤害。长期酗酒的人比不饮酒的人更容易患上肝癌。
4、脂肪肝
许多人对脂肪肝问题无视不计,《中国脂肪肝防治指南》的统计数据显现,中国成年人的脂肪肝患病率在12.5%至35.4%之间,超越2亿人患有这种疾病。脂肪肝患者群体也在不时增加,长期患有脂肪肝而不加干预,也存在一定的肝癌风险。
在生活中,我们应尽可能防止上述可能招致肝癌的风险要素。关于曾经被确诊患有肝癌的患者来说,他们最关怀的问题是可以活多久。

四、肝癌确诊后,生存期有多长?
1、类型
肝癌可分为原发性和转移性两种,原发性肝癌又可分为肝细胞型、胆管细胞型和混合型。依据肿瘤的形态,还可分为结节型、巨块型和洋溢型。不同类型的肝癌具有不同的病症和腐蚀水平,因而生存期也会有所不同。
2、分期
肝癌依据疾病的停顿水平可分为早期、中期和晚期三个分期。假如肝癌可以早期发现并及时停止治疗,有望取得与常人相当的生存期。早期肝癌假如可以采取根治性手术,5年生存率可到达95%以上。但是,中晚期肝癌的治疗较为艰难,但假如采用科学的治疗办法,依然有时机进步生存质量和延长生存期。
3、转移部位
肝癌的转移可经过淋巴转移、种植转移和血行转移等方式停止。不同的转移途径和部位对身体的腐蚀水平和病症也会有所差别。因而,在治疗和康复过程中,也需求依据详细状况停止个体化的治疗计划和康复方案。也会存在差别。假如肝癌扩散到重要部位,可能会对患者的生命平安构成严重要挟。
4、患者体质
患者的生存期与其本身的体质有很大的关联。身体素质良好、免疫力强且没有根底性疾病的患者,在治疗后恢复速度较快,生存周期也会相应延长相反,患者的身体素质较差或存在根底性疾病,可能会招致生存期的缩短。
总的来说,肝癌患者在确诊后能活多久没有确切的定论,这是由多个要素共同决议的。因而,在确诊后,患者应积极配合医生停止治疗,并坚决打败病情的决计。


